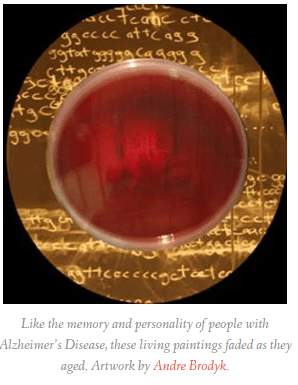
Screenshot 2016-08-14 at 17.33.19.png

Culture Report: The Beauty of Bacteria – Kinsee Morlan – Voice of San Diego
(I)t wasn’t the rising international excitement over the microbiome that got San Diego artist Sara Parent-Ramos interested in the subject, nor was it the fact that both her parents are microbiologists. What finally made the artist and new mom really start to think about the microbiome was her own breast milk and all the beneficial bacterium swimming in it.

Breaking The Molds: See Microbes As Art – Susan Karlin – FastCoCreate
For most folks, microbes and mold conjure unsavory images of outbreaks and dirty bathrooms. But two Southern California exhibits are proving that one person’s contagion is another one’s canvas.Taking Art to the Cellular Level features 20 enlarged microscopic visuals from Southern California research. Breaking the Molds: TTOZOI in Evolution is a kind of painting by organic mold.

Works of art made of… microbes!
Our relationship with microbes and viruses is in a state of change. (…) Concordia University communications researcher Tagny Duff is exploring this relationship with BioreMEDIAtion, a research-creation project that lies at the intersection of art and the life sciences and seeks to expand our relationship with the microscopic living world through art.
–
Bacteria Genome Dresses and Judgmental Robots Probe Tech Boundaries – Kevin Holmes – The Creators Project
Virtual reality, biofeedback devices, and artificial intelligence: all rapidly developing industries and areas that involve a human-computer relationship. How that relationship will evolve is an intriguing question that’s currently being played out at the hands of big tech firms and startups. It’s also the focus of an exhibition, The Games Europe Plays, currently on at the Stephen Lawrence Gallery at the University of Greenwich, London. The show has been curated by Ghislaine Boddington, creative director of body>data>space, and a Reader in Digital Immersion at the uni.

Not really microbial but sort of (because CRISPR): Who Is Afraid of CRISPR Art? – Eben Kirksey – Anthropology and Environment Society
A crowd-sourced Indiegogo funding campaign that raised over $45,000 for do-it-yourself gene editing kits in December, asks: “If you had access to modern synthetic biology tools, what would you create?” This campaign, which aims to democratize science “so everyone has access,” was launched by Josiah Zayner, who earned a PhD in Molecular Biophysics from the University of Chicago.

ASM Agar Art Calendar 2016/2017 – American Society for Microbiology (Unfortunately already sold out).
Featuring the winners of the 2015 Agar Art Contest, along with People’s Choice winners, the Agar Art Calendar is a first of its kind.
